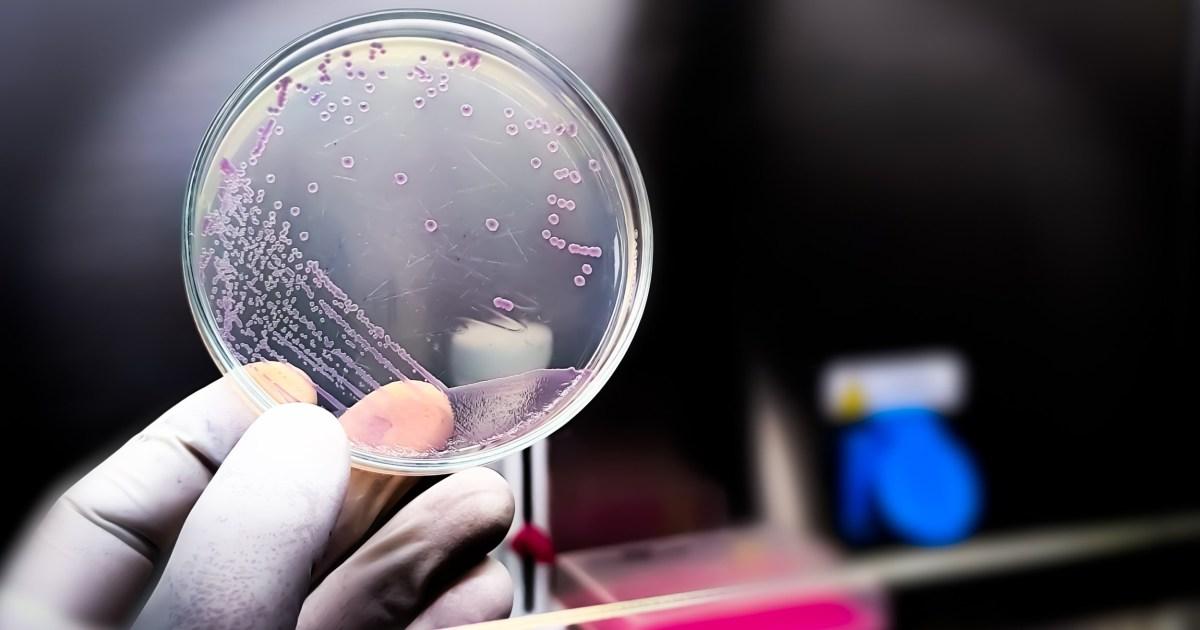
New virus with genetic code written by AI 'is first step towards lab-grown life' | News Tech

Evo-Φ2147 defeated the E. Coli in a petri dish (Credits: Getty Images)
Scientists have made the first step towards creating new species in the lab.
Researchers have used artificial intelligence to create a new virus to attack a colony of the deadly E.coli bacteria.
The team at Stanford University, California used AI to draw up the entire genome for the virus, codenamed Evo-Φ2147.
The breakthrough in synthetic biology marks the moment when Darwinian evolution could be upended, and new species could be brought to life from a petri dish.
Adrian Woolfson, a British molecular biologist and tech entrepreneur, told the Sunday Times: ‘This is a massive, consequential moment.
‘For the last four billion years evolution has been blind — there has been no foresight, there has been no intentionality.
‘Now, instead of discovering species that have evolved in this ad hoc manner, suddenly we can make life — yes in a rudimentary way, but the process has begun.

The new virus’ genome was created using AI (Picture: Arc Institute)
‘This is not speculation. It’s not futuristic, it is happening.’
Evo-Φ2147 was one of 285 new viruses created by the AI program Evo2.
They were all put in petri dishes, with 16 managing to attack the the E.coli.
A mixture of all 16 strains was even able to defeat the most resistant forms of the deadly bacteria.
Evo-Φ2147 is not quite ‘life’ because it cannot reproduce outside of a host and contains 11 genes compared to 20,000 in a human.
But it represents a proof of concept that genomes can be designed in their entirety.
A genome is the complete set of genetic instructions (DNA) found in an organism, containing all the information required for it to develop, function, and reproduce.
Woolfson, 60, and his team at Genyro, are pioneering work in this field.
Members of the team were behind a new DNA construction tool unveiled in the journal Nature on Wednesday.
Scientists from the California Institute of Technology said the tool, called Sidewinder, can build long genetic sequences up to 100,000 times more accurately than anything developed before.
Discussing the breakthrough, Kaihang Wang, 43, said: ‘If you can control the source code of life, you can create anything and everything.

The new technology could be the first step to creating new species in a lab
(PIcture: Getty Images)
‘The only thing limiting it is our imagination.’
These two technologies together could lead the way for a revolution in medicines, materials, and evolution itself.
Woolfson believes it could be used to create new species and bring back extinct creatures.
Had the technology been around during the Covid pandemic, researchers believe it would have allowed them to make the first mRNA vaccine in just 62 hours, rather than the 42 days it took in 2020.
These new scientific innovations are groundbreaking but come with security concerns that require ‘responsibility’, Woolfson says.
For example, the Evo2 model was not trained using viruses that are pathogenic to humans.
Woolfson added: ‘Humankind needs to decide who is going to define the guard rails.
‘Who is going to decide what gets written? Who’s going to decide on the governance? Society needs to know this is happening, so people can have these conversations.’
Get in touch with our news team by emailing us at webnews@metro.co.uk.
For more stories like this, check our news page.
Arrow
MORE: How did an AI-generated purple-haired goth become a symbol for the UK far right?
Arrow
MORE: King’s intervention ‘was behind Trump’s backtrack over jibe at UK troops’
Arrow
MORE: Almost 90 arrested over mass trespass at prison in support of hunger striker
Comments
Add Metro as a Preferred Source on Google
Add as preferred source
Puzzles Newsletter
Get your favourite puzzles when they are ready to play on the website sent directly to you every day and track your daily streak!